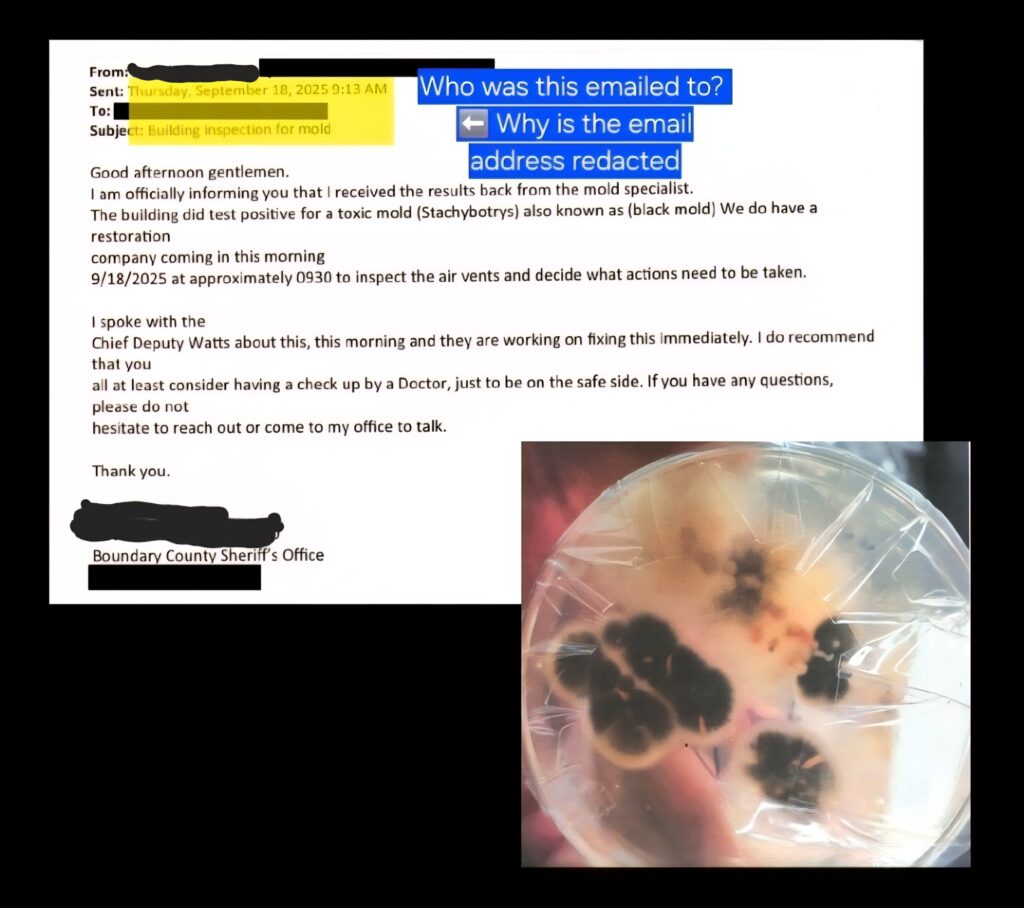
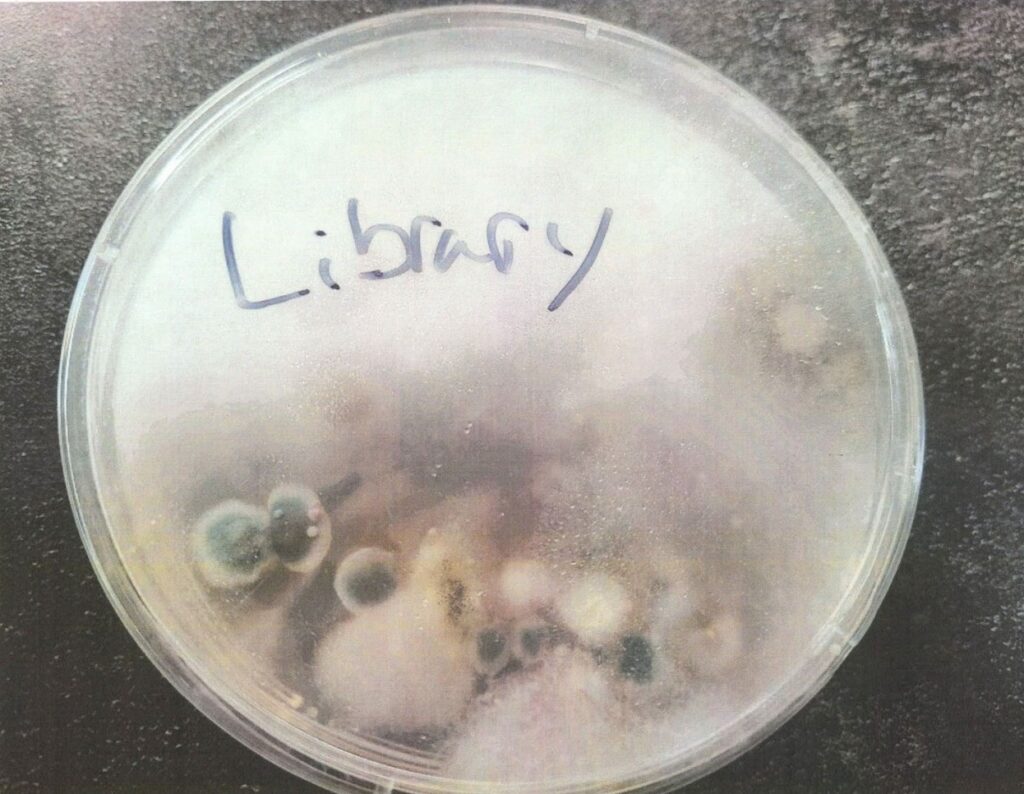
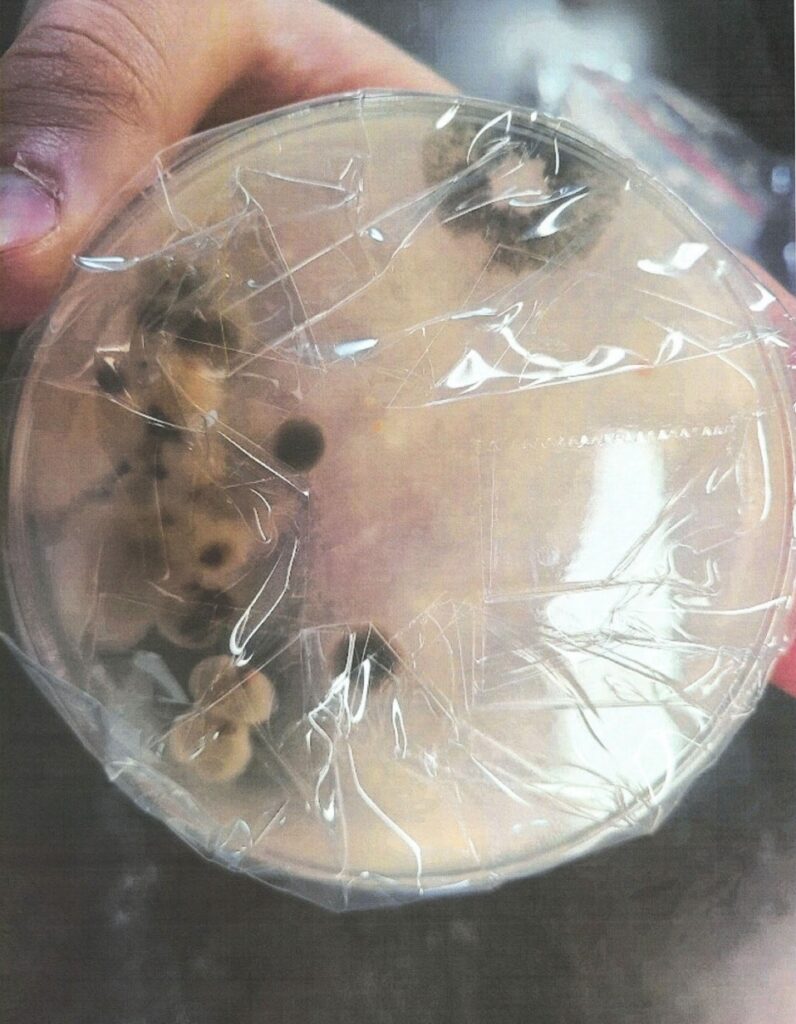
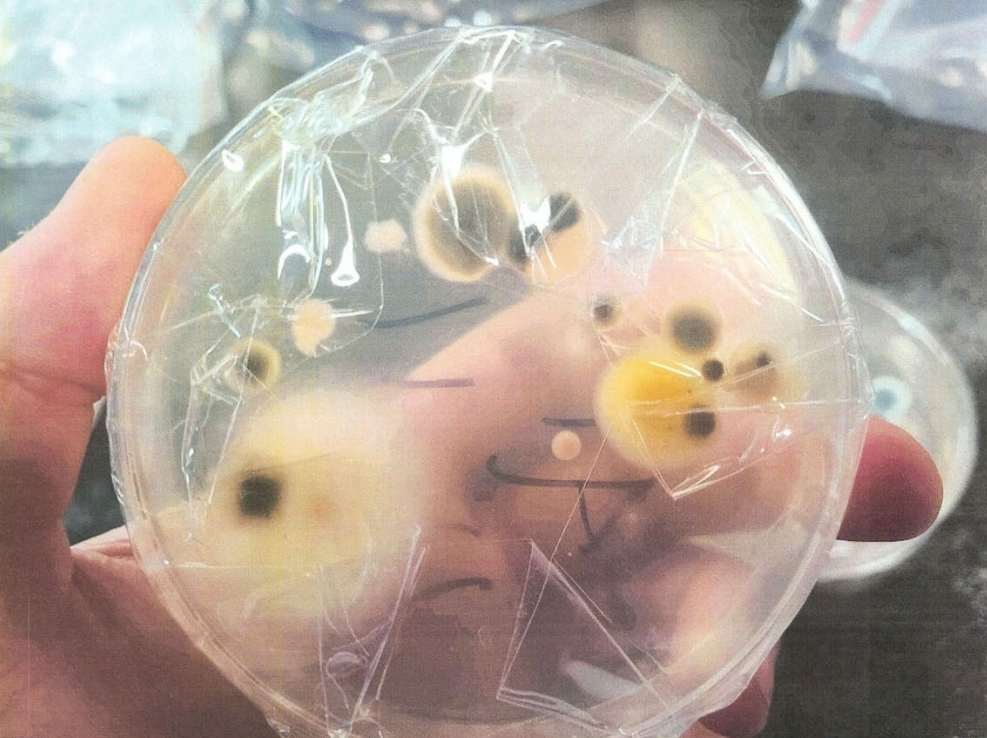
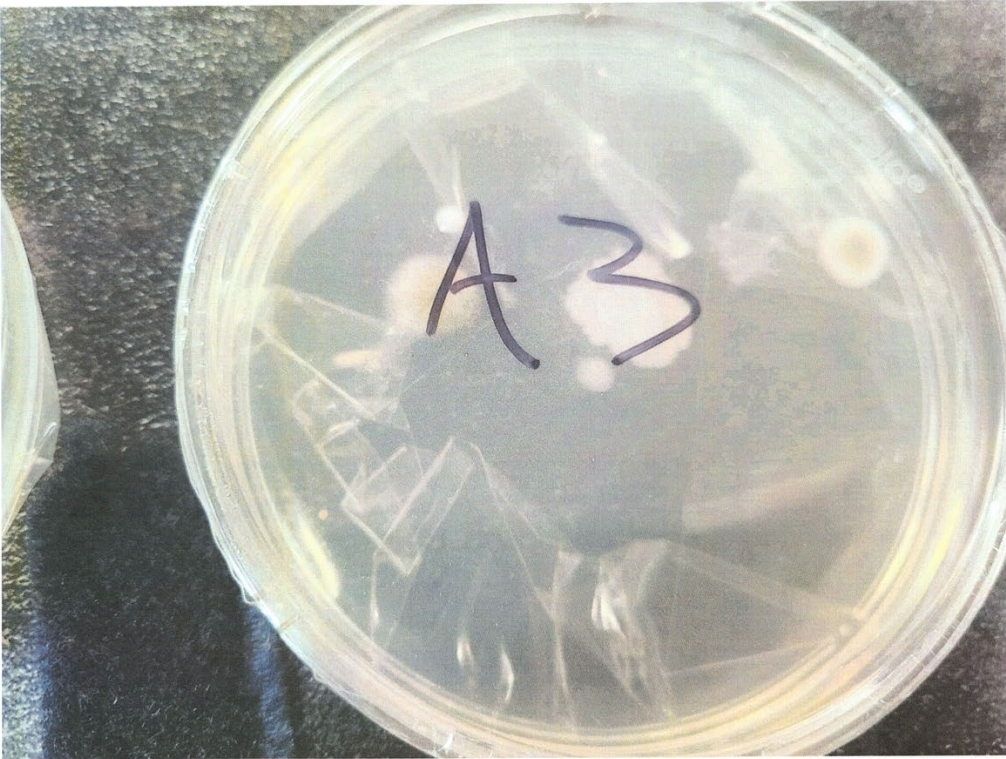
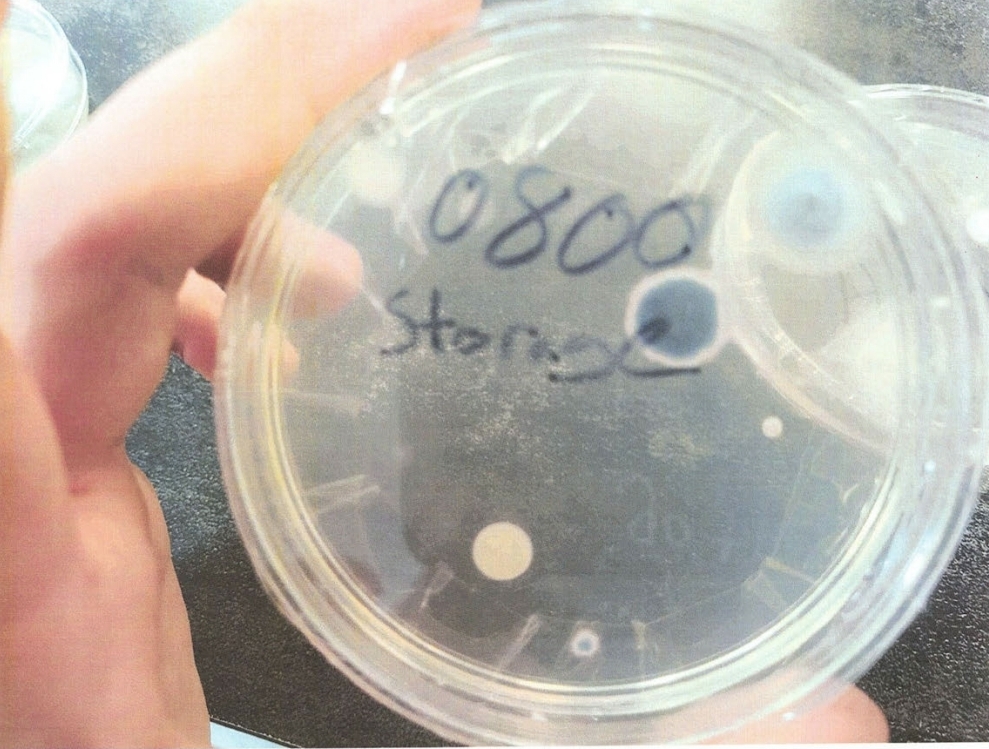
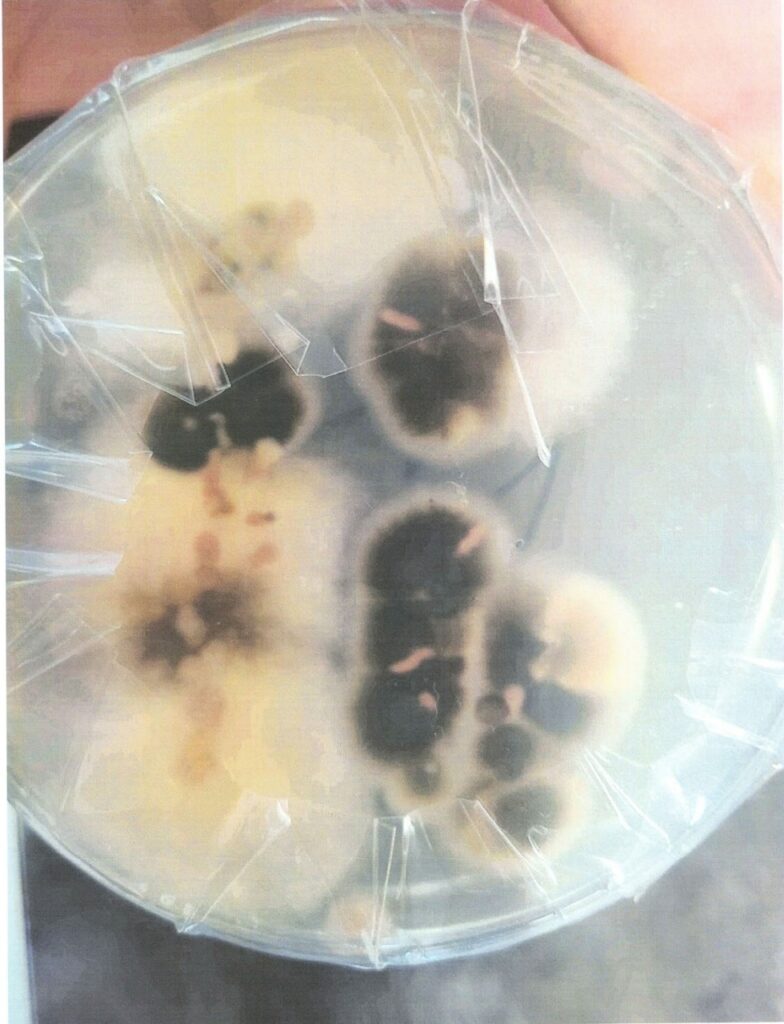
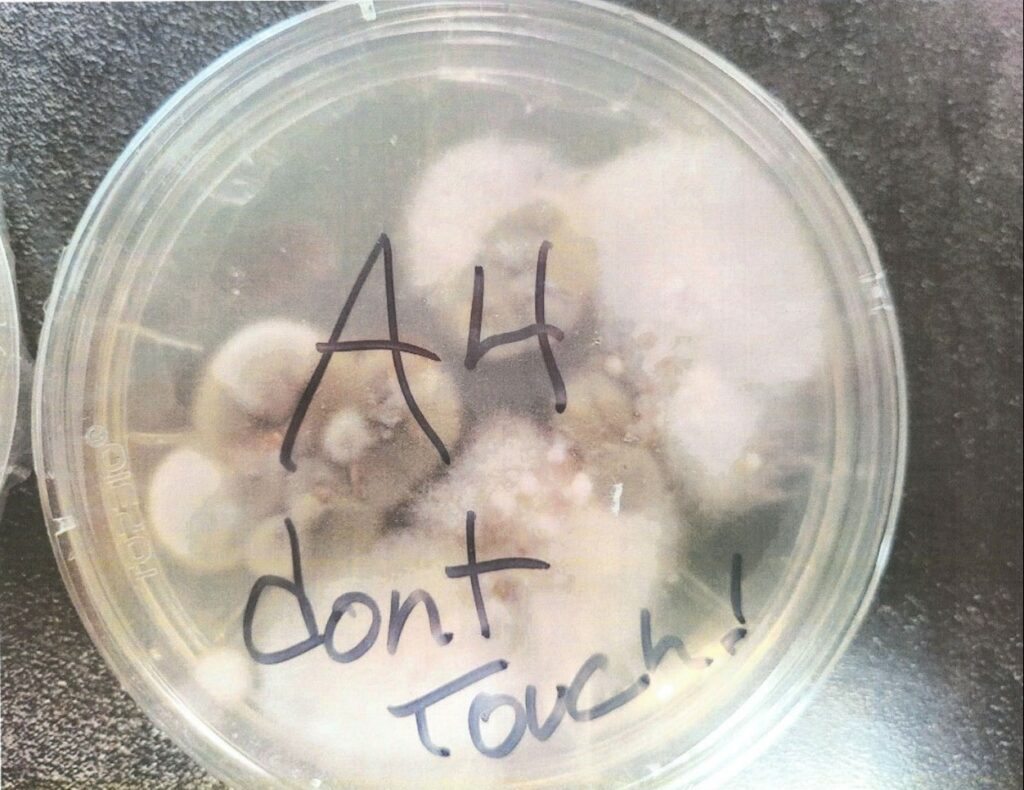
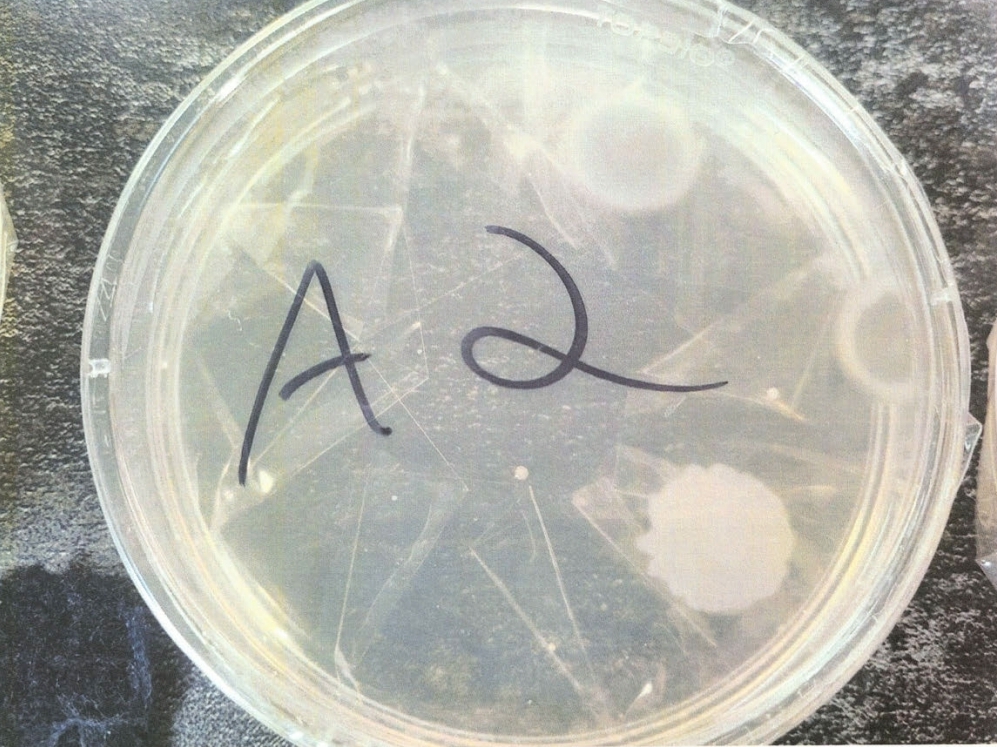
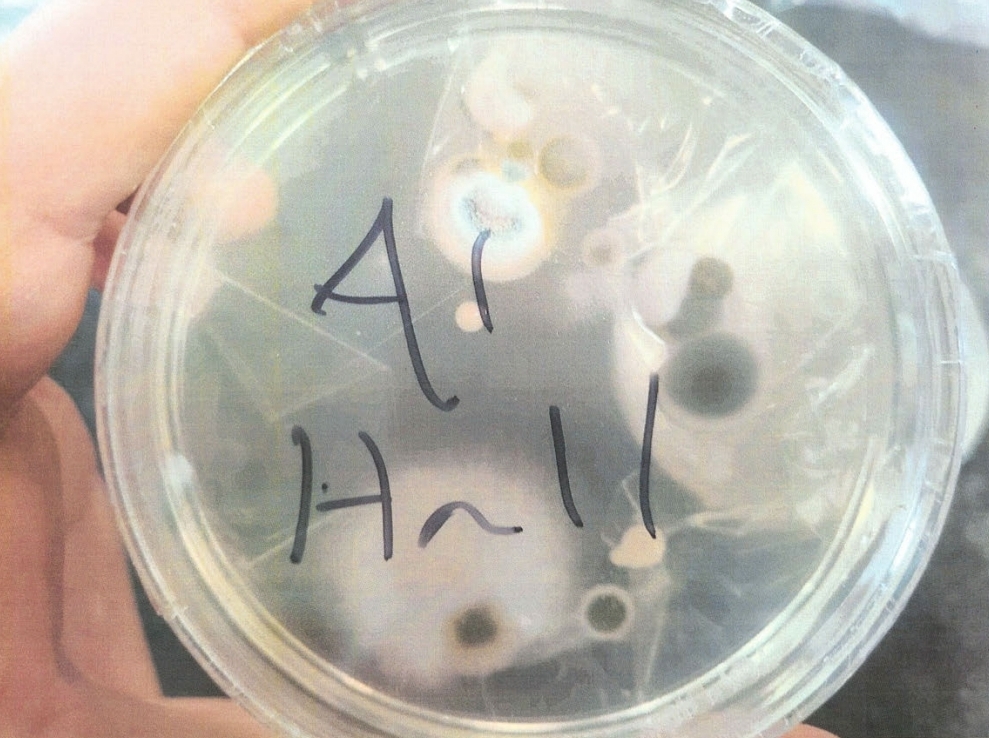
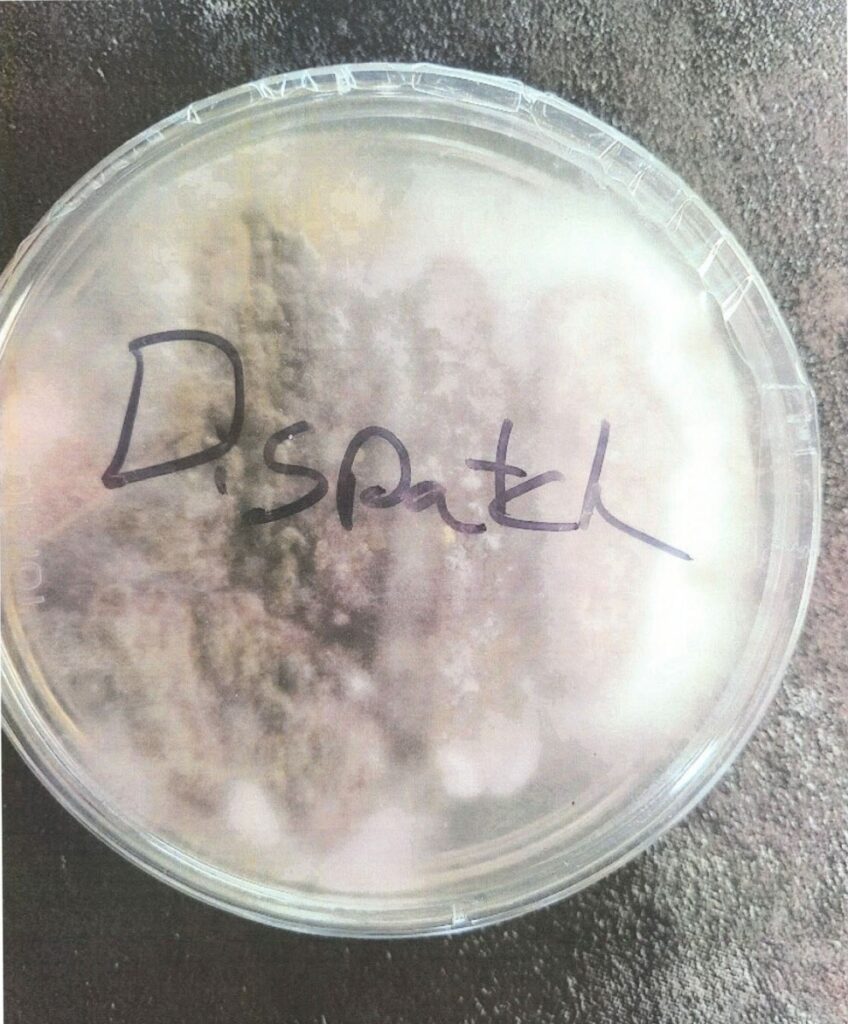
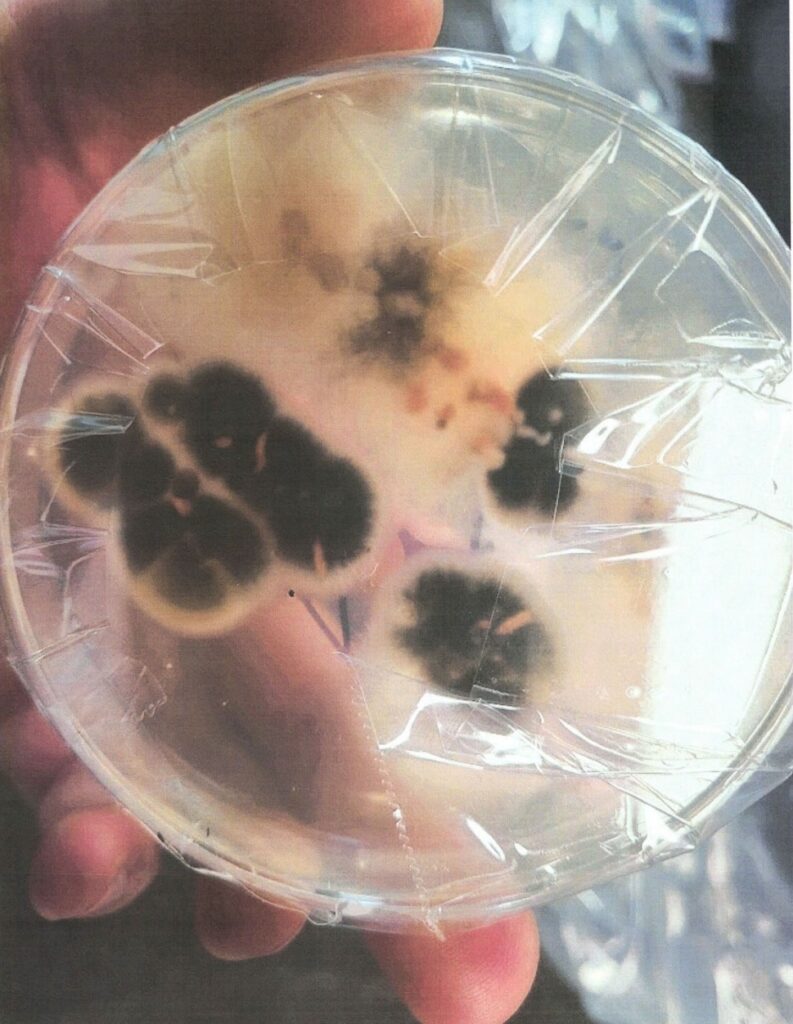
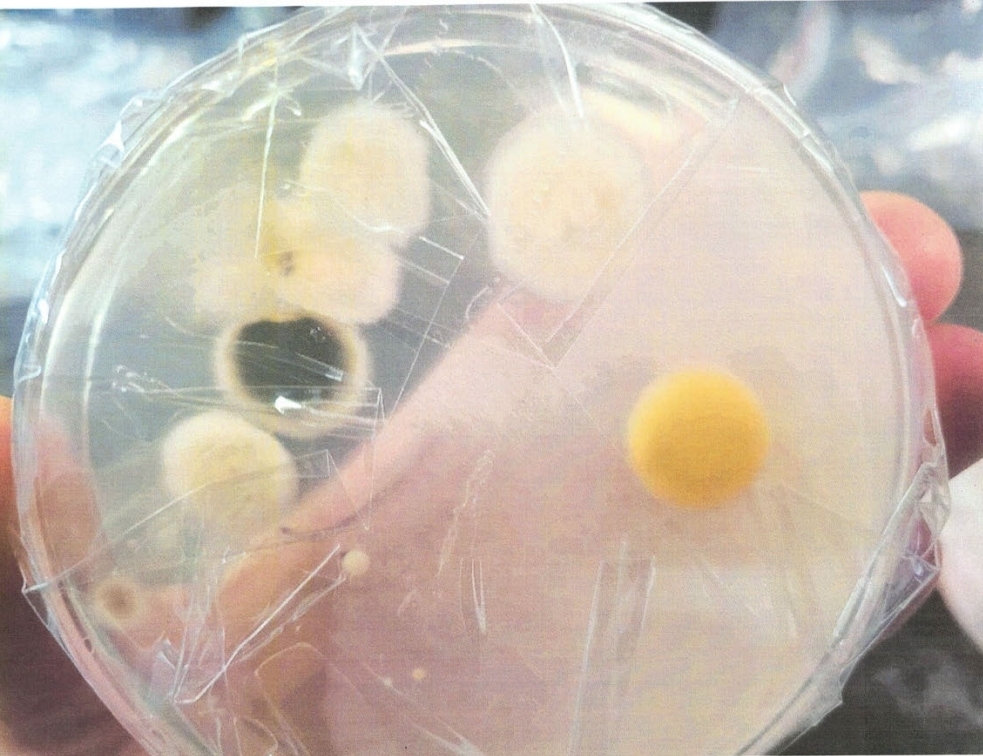
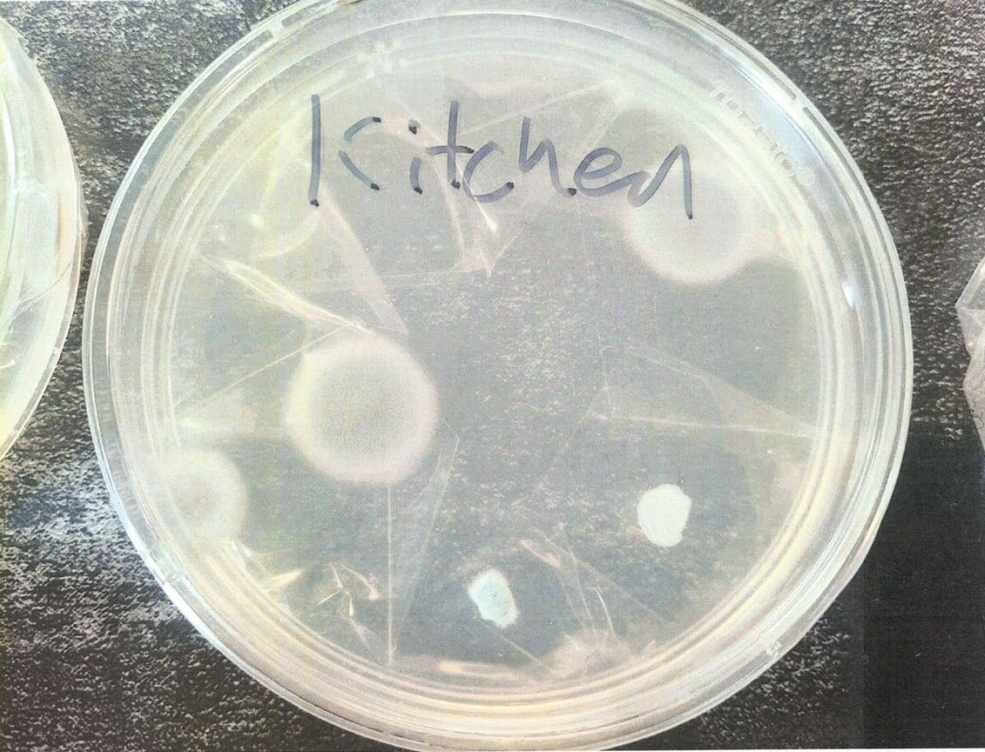
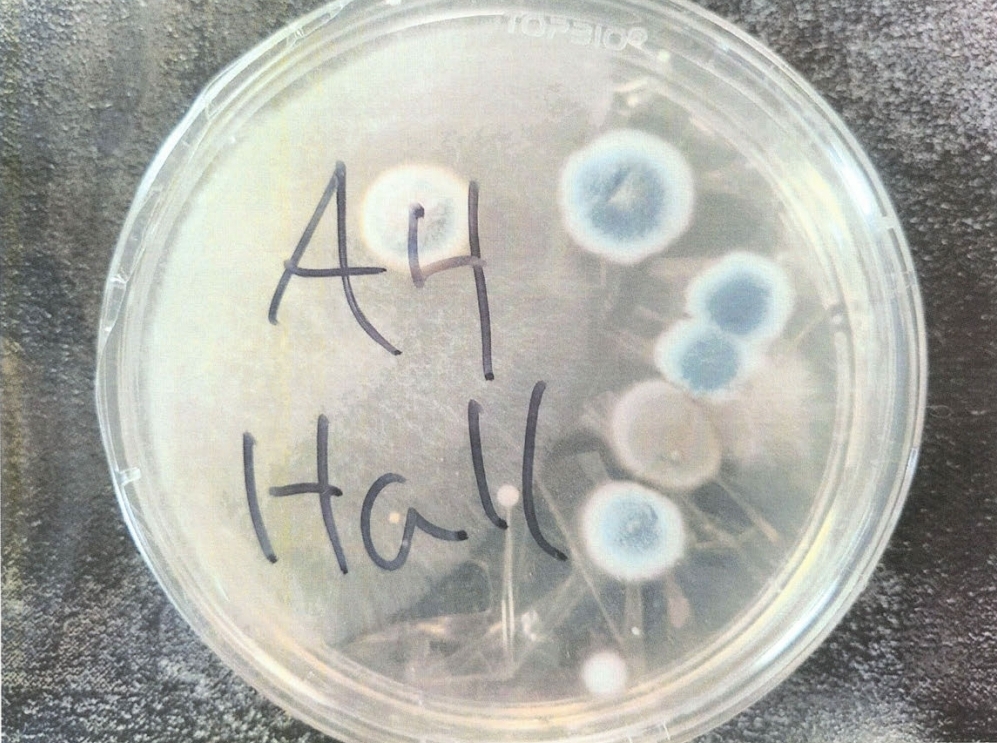

Commissioners’ Meeting Minutes – December 29, 2025
Sheriff Travis Stolley and Chief Deputy Caleb Watts entered the meeting at 11:00 a.m. and Sheriff Stolley stated that he wanted to discuss the maintenance and condition of the jail. It was an older building with several issues. One of which was a moisture issue in the upper level of the building. They have had an inspection and he provided two quotes to clean what was going on. He stated that the new roof fixed some of the issues, but moisture was getting trapped. They are looking at dehumidifiers to help address the problem. Sheriff Stolley added that there are also wiring issues, the kitchen stove was not working again and there were multiple plumbing issues. Sheriff Stolley stated it was just a matter of time before there was a complete failure.
He then said that a feasibility study was done to replace the jail and two locations were proposed. They designed a 60-person facility with offices and noted that dispatch would also be included. He stated that one of the proposed locations creates a logistics problem for court, so he felt the downtown location was best.
They typically house 24-25 inmates and this was the first month they have been below capacity in a while with 12 inmates. We are at a tipping point, the building is old and the infrastructure is failing. He then asked where are we at with funding a new jail and how do we proceed.
Chairman Robertson stated that he wanted to see what the legislature does this year. Sheriff Stolley stated he was also interested in what they would do. He then asked if it passes what happens next, what do we do in the meantime, and when would it take place. He wanted a plan in place now so we know what to do when funding was available. Sheriff Stolley then asked if there were things he could do on his own or if the Commissioners were in charge of that. Commissioners stated that the funding commitment would come from them and there was a statute that defined the bid process. Commissioners added that they need to know what they are going to build before they pursue funding.
Commissioner Pinkerton stated that the costs jump significantly once you get into it. He asked if there was a footprint out there than could be used. Chairman Robertson and Commissioner Bertling agreed and provided examples. Commissioner Pinkerton then asked if they could receive funding for housing state or federal inmates. Sheriff Stolley stated yes, and he would like to consider that. Chairman Robertson stated that a bigger facility comes with higher costs. He then asked if you still get funding if the cells are empty. Sheriff Stolley stated that the state portion would be housed, but federal might be different. There would be a loss because it would require more staff in place whether inmates are there or not. The food contracts are also variable because you have to have the contract whether or not you have inmates.
Commissioner Pinkerton stated he was interested in pursuing, but there were limitations. You will have to draw this back. Chairman Robertson stated the only option was to run a bond. Sheriff Stolley stated that they could also pursue grants, but that would be limited.
Commissioner Pinkerton said you have to talk to the legislatures. Sheriff Stolley agreed, and added that they tried last year but it didn’t move forward so we are trying again. He also added that he could put together a community action board, but they would need information to push out.
Chairman Robertson stated that it would be at least 2027 before it could be considered for an election. Ms. Poston added that you would need figures before an election. You have a lot of work to do.
Sheriff Stolley asked about the maintenance and operation side. He stated that he wanted to begin increasing his staffing so he was ready for a new facility and asked about using Opioid funds. Ms. Poston stated that those funds are not long term and would be eaten up really fast. They would then be gone. That was not a long-term solution.
Sheriff Stolley discussed the number of employees that he would need. Chairman Robertson stated that this was discussed a couple years ago when the study was done. We are looking at a minimum of a three-year process and possibly more. The only position to consider for next year was a float person for court/detention. Ms. Poston agreed and said that would be needed next year when they are in the new location.
Sheriff Stolley asked about the state funding the court position. Ms. Poston replied no, the state only provides the computer. The county pays for the staff. Chairman Robertson stated that you need to get in the legislature’s ear.
Sheriff Stolley stated he would reach out to others to gather more information.
The meeting with Sheriff Stolley ended at 12:05 p.m. and he and Chief Deputy Watts left the meeting.
Link:
https://boundarycountyid.org/…/commissioners-meeting…
******************************
January 16, 2026
The Boundary County Sheriff’s emails assert the presence of Black Mold. In response to my public records request submitted in December, the County stated that no written or emailed complaints from department employees existed. However, the public records I received one month later directly contradict that claim. Under Idaho Code § 74, those records should have been acknowledged and disclosed.